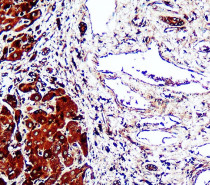

ARG67099
anti-Perilipin 1 antibody
anti-Perilipin 1 antibody for IHC-Formalin-fixed paraffin-embedded sections,Western blot and Human,Mouse,Rat
Overview
| Product Description | Rabbit Polyclonal antibody recognizes Perilipin 1 |
|---|---|
| Tested Reactivity | Hu, Ms, Rat |
| Tested Application | IHC-P, WB |
| Host | Rabbit |
| Clonality | Polyclonal |
| Isotype | IgG |
| Target Name | Perilipin 1 |
| Immunogen | Synthetic peptide |
| Conjugation | Un-conjugated |
| Alternate Names | Perilipin-1; PERI; Lipid droplet-associated protein; PLIN; FPLD4 |
Application Instructions
| Application Suggestion |
|
||||||
|---|---|---|---|---|---|---|---|
| Application Note | * The dilutions indicate recommended starting dilutions and the optimal dilutions or concentrations should be determined by the scientist. | ||||||
| Observed Size | ~ 68 kDa |
Properties
| Form | Liquid |
|---|---|
| Purification | Affinity purified. |
| Buffer | 100 mM Tris Glycine (pH 7.0), 0.025% ProClin 300, 20% Glycerol and 1% BSA. |
| Preservative | 0.025% ProClin 300 |
| Stabilizer | 20% Glycerol and 1% BSA |
| Concentration | 1.26 mg/ml |
| Storage Instruction | For continuous use, store undiluted antibody at 2-8°C for up to a week. For long-term storage, aliquot and store at -20°C. Storage in frost free freezers is not recommended. Avoid repeated freeze/thaw cycles. Suggest spin the vial prior to opening. The antibody solution should be gently mixed before use. |
| Note | For laboratory research only, not for drug, diagnostic or other use. |
Bioinformation
| Database Links | |
|---|---|
| Gene Symbol | PLIN1 |
| Gene Full Name | perilipin 1 |
| Background | The protein encoded by this gene coats lipid storage droplets in adipocytes, thereby protecting them until they can be broken down by hormone-sensitive lipase. The encoded protein is the major cAMP-dependent protein kinase substrate in adipocytes and, when unphosphorylated, may play a role in the inhibition of lipolysis. Alternatively spliced transcript variants varying in the 5' UTR, but encoding the same protein, have been found for this gene. [provided by RefSeq, Feb 2009] |
| Function | Modulator of adipocyte lipid metabolism. Coats lipid storage droplets to protect them from breakdown by hormone-sensitive lipase (HSL). Its absence may result in leanness. Plays a role in unilocular lipid droplet formation by activating CIDEC. Their interaction promotes lipid droplet enlargement and directional net neutral lipid transfer. May modulate lipolysis and triglyceride levels. [UniProt] |
| Cellular Localization | Endoplasmic reticulum. Lipid droplet. Note=Lipid droplet surface-associated. [UniProt] |
| Calculated MW | 56 kDa |
| PTM | Major cAMP-dependent protein kinase-substrate in adipocytes, also dephosphorylated by PP1. When phosphorylated, may be maximally sensitive to HSL and when unphosphorylated, may play a role in the inhibition of lipolysis, by acting as a barrier in lipid droplet (By similarity). [UniProt] |
Images (4) Click the Picture to Zoom In
-
ARG67099 anti-Perilipin 1 antibody IHC-P image
Immunohistochemistry: Human cancer stained with ARG67099 anti-Perilipin 1 antibody at 1:100 dilution.
-
ARG67099 anti-Perilipin 1 antibody WB image
Western blot: Human adipose stained with ARG67099 anti-Perilipin 1 antibody at 1: 1500 dilution.
-
ARG67099 anti-Perilipin 1 antibody IHC-P image
Immunohistochemistry: Mouse adipose stained with ARG67099 anti-Perilipin 1 antibody at 1:200 dilution.
-
ARG67099 anti-Perilipin 1 antibody WB image
Western blot: Mouse adipose stained with ARG67099 anti-Perilipin 1 antibody at 1: 1500 dilution.